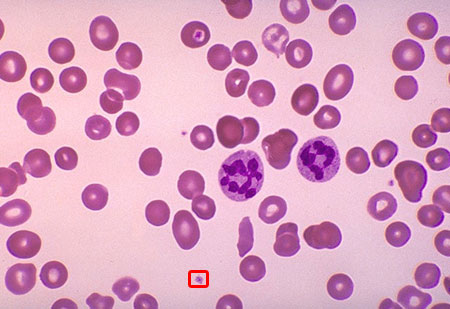

|
Medical
Student Corner
Menorrhagia & Easy Bruising
You are asked
to evaluate a 19-year old white female who presents to your office with
the chief complaint of menorrhagia and easy bruising.
Since the
onset of menses at age 13, she has used approximately 9 pads per day for
seven days during each menstrual cycle. She has also noted the frequent
development of large (>3 cm) ecchymoses due to minor trauma since early
childhood, along with bleeding gums when brushing her teeth vigorously,
and occasional nosebleeds.
Other than
these issues, she has no medical problems, and has never had major surgery.
She takes
no medications and has no known drug allergies; she does not smoke or
drink alcohol, and is a sophomore in college, where she lives with a roomate.
Her family history is significant in that her mother also had multiple
bleeding problems, and suffered from severe menorrhagia throughout adolescence
as well. In addition, a maternal great aunt died of post-operative bleeding
in the 1940's.
On physical
exam, the patient is in no apparent distress, and is very pleasant.
Temperature
is 97.7F, pulse is 80, blood pressure is 120/70, and respirations are
12.
There is
a 3 cm ecchymosis on her left upper arm, as well as a smaller one on her
right shin.
Head and
neck, lung, heart, and abdominal exams are normal, as is a pelvic exam.
Screening
laboratory studies show a moderate microcytic anemia. The remainder of
the tests, including PT/PTT and platelet count, are reported to be normal.
Hazily remembering
something you learned during your medical school years, you visit the
lab yourself and examine the patient's peripheral blood smear at 10x magnification:
Viewing the
outlined area at 500x magnification, you discover the following:

What's
going on?
Answer:
Von Willebrand's Disease
This woman,
who presented with menorrhagia and easy bruising, has von Willebrand's
Disease.
The presence
of Finnish physician Dr. Erik von Willebrand in the patient's platelets
is demonstrated in the high-power view above, and is pathognomonic for
the disorder.
Without a
strong clinical suspicion, clinicians often neglect to utilize the 500x
magnification lens necessary to visualize platelets containing Dr. von
Willebrand with conventional light microscopy. Even then, von Willebrand
is often mistaken for the Golgi apparatus, endoplasmic reticulum, or other
typical cell structure, leading to an unnecessary delay in diagnosis.
It is important
to remember that, while Dr. von Willebrand is most likely to be found
in a classic frontal portrait pose, it is not unusual to see him lying
comfortably on his side, or playing a round of golf with his friends.
The diagnosis
can be confirmed by in vitro ristocetin challenge, which will cause
von Willebrand's hair to become visibly stringy and dry, eventually falling
out in clumps.
Treatment
is straightforward and involves intravenous desmopressin (DDAVP), a substance
which gently persuades Dr. von Willebrand to leave the affected platelets
and return to his native village in the Scandanavian hinterland.
|